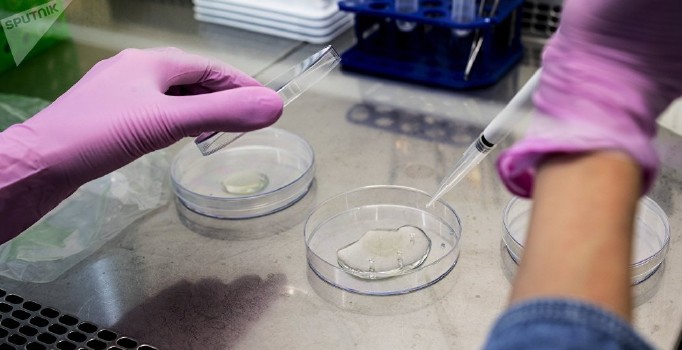
Kanser hücrelerinin yayılmasını engelleyen ilaç geliştirildi

Sant Pau Biyomedikal Araştırma Enstitüsü ile Barselona Üniversitesi’ne bağlı biyomühendislik, biyomateryaller ve nanotıp uzmanlarından oluşan bir ekip kanser hücresinin yayılmasını engelleyen bir ilaç geliştirdiler. İlacı kobay hayvanlarda deneyen bilim insanları başarıya ulaştı.
DÜNYADA BİR İK
Araştırmacılar ilk kez metastatik kök hücreleri seçici olarak ortadan kaldıran bir nanoplikasyonun geliştirmiş oldu. Çalışma kolorektal kanserde metastazın önlenmesi için yeni bir çığır açacak. Yapılan açıklamaya göre, ilaç nanotıp, metastatik kök hücrelerde bir reseptörü tanımlayan, ilacı yöneten ve sadece bu hücreleri yok eden bir drone gibi çalışıyor.
Sadece metastatik tümör hücreleri üzerinde hareket ederek, yeni ilacın kansere karşı genel tedavilerle ilişkili genel toksisiteyi önlüyor ve sağlıklı hücreleri koruyor.
HENÜZ TEST AŞAMASINDA
Araştırma umut verici olmasına rağmen hala erken bir aşamada. Ekibin Başkanı Arjantinli başkan Ubaldo Alfredo Gualdrini, “H er ne kadar yeni araştırmanın yayılmasını teşvik etsek de, bu bilgiyi aceleci buluyoruz. Çünkü ilacın klinik bir pratiği henüz yok” açıklamasında bulundu.
Dünyada kanser hastalarında ölümün ana nedeni metastatik yayılım olarak kabul ediliyor. Halen metastatik kök hücreleri seçici olarak ortadan kaldıran kabul edilmiş bir ilaç bulunmuyor. Bu nedenle yeni ilaç, insanlarda test edildikten sonra yüksek bir klinik etkiye sahip olacak.
İlaç, kolorektal kanser ve akut miyeloid lösemi üzerinde test edildi. Ancak araştırmacılar analiz edilen tümörlerin çoğunda, CXCR4 reseptörünün metastatik kök hücrelerde aşırı eksprese neden olduğunu açıklamakta.
Ne var ki, prostat, meme, yumurtalık ve pankreas kadar yaygın olmayan 20 farklı tip tümörle korelasyon olduğunu da kabul ediyorlar.
MADRİD/İHA